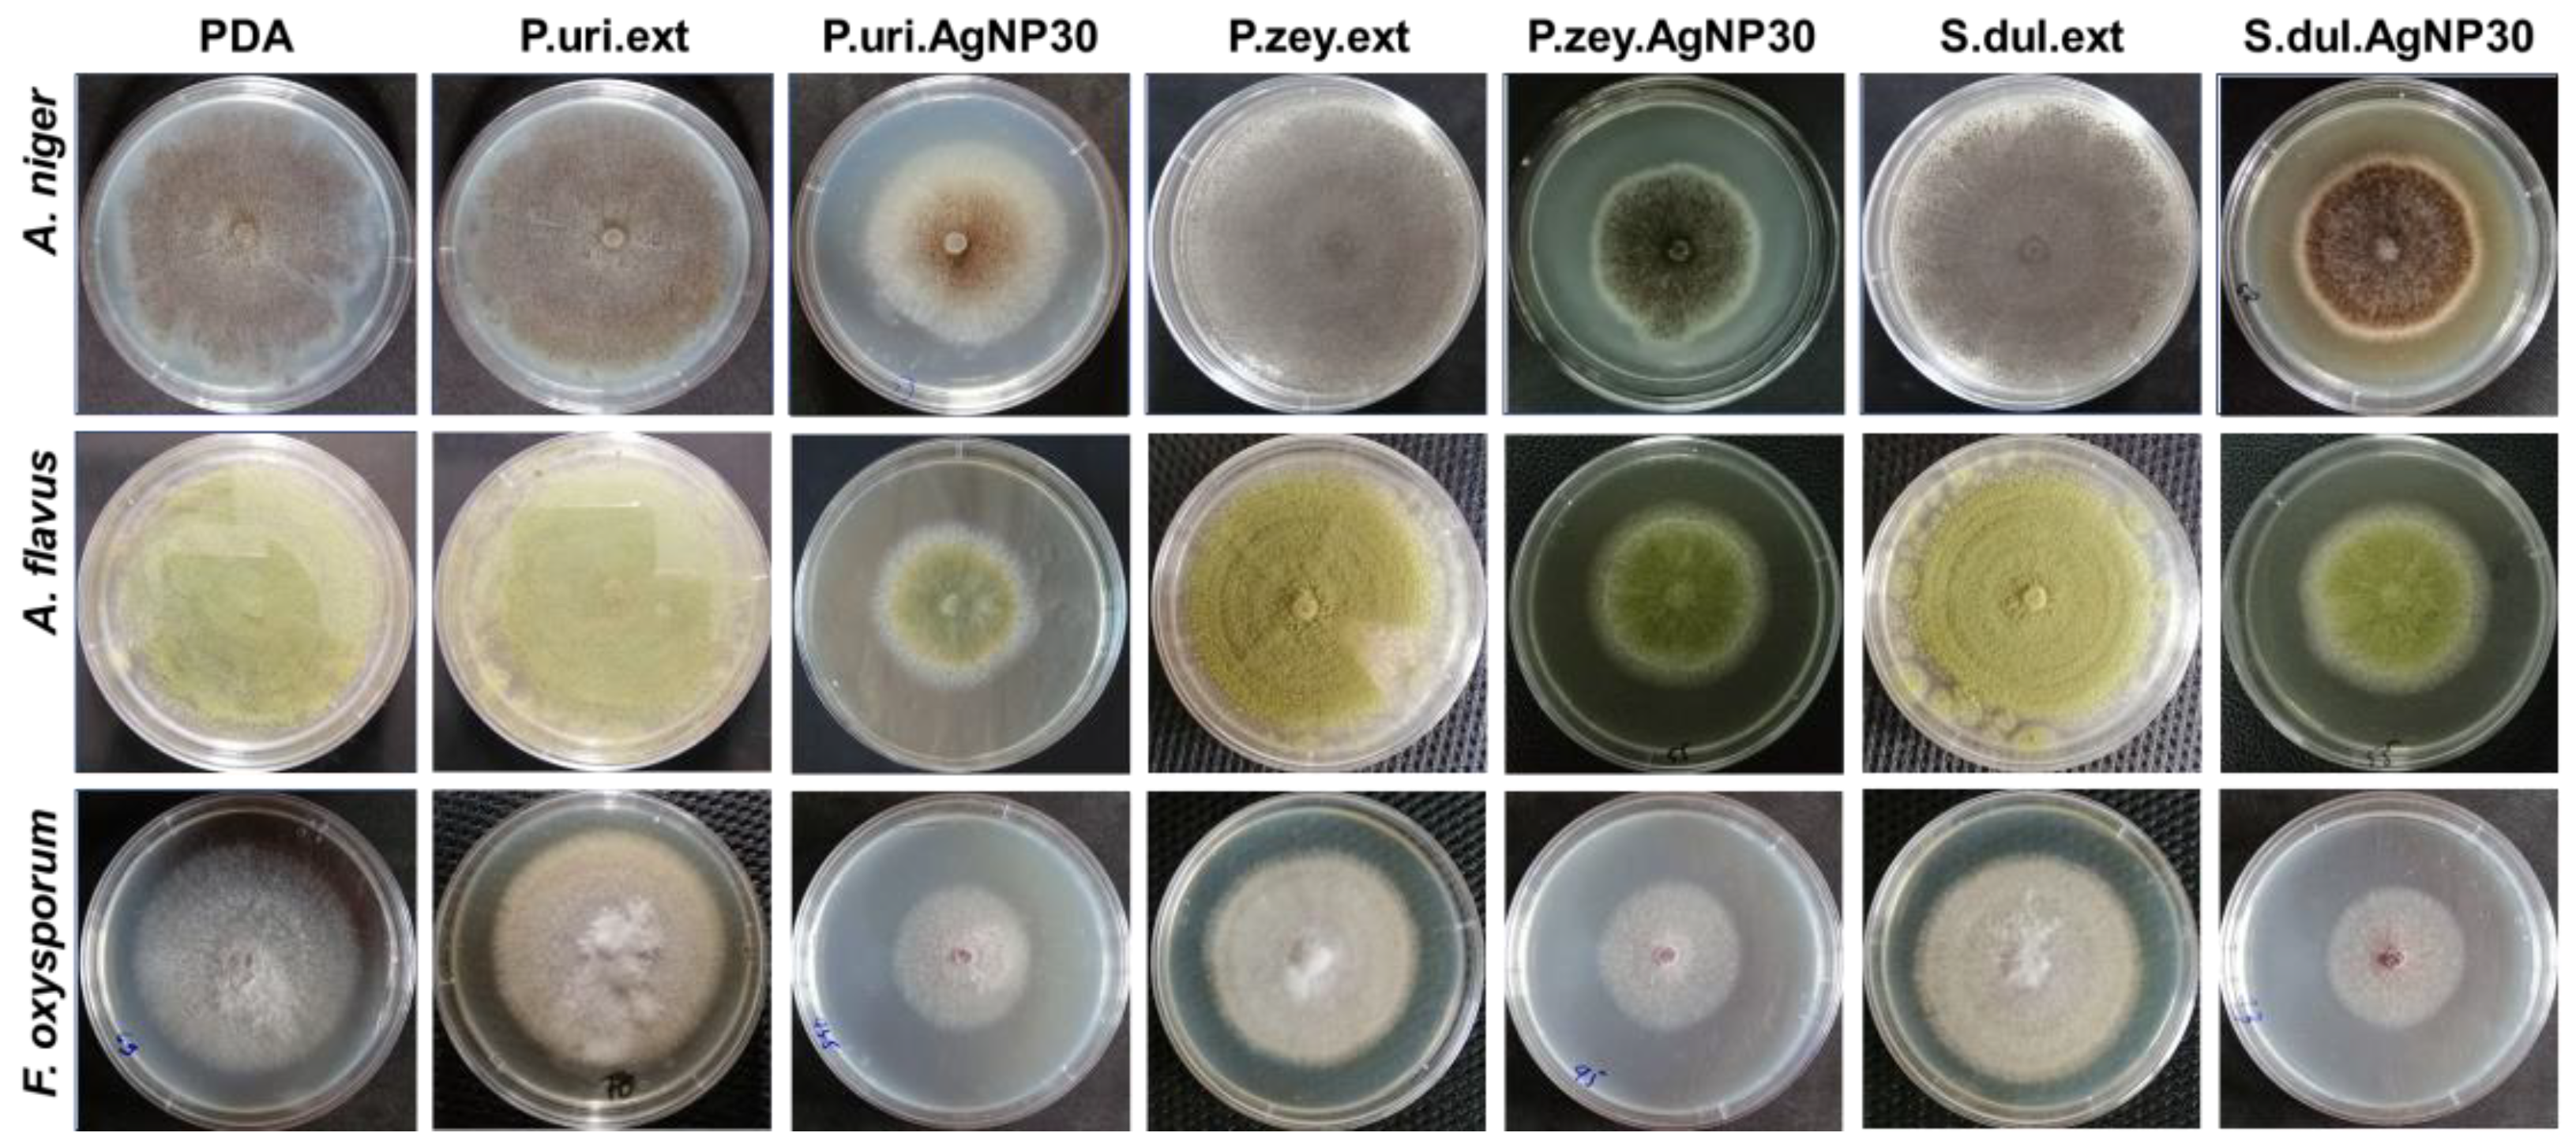
Nanomaterials 14 00475 g004

Error in Figure
In the original publication [1], there was a mistake in Figure 4 as published. An error occurred when we arranged the images, resulting in the display of two identical images. The corrected Figure 4 appears below. The authors state that the scientific conclusions are unaffected. This correction was approved by the Academic Editor. The original publication has also been updated.

Figure 4.
Three fungal strains including A. niger, A. flavus, and F. oxysporum were culture in different agar matrix after 96 h.
Reference
- Nguyen, D.H.; Lee, J.S.; Park, K.D.; Ching, Y.C.; Nguyen, X.T.; Phan, V.H.G.; Hoang Thi, T.T. Green Silver Nanoparticles Formed by Phyllanthus urinaria, Pouzolzia zeylanica, and Scoparia dulcis Leaf Extracts and the Antifungal Activity. Nanomaterials 2020, 10, 542. [Google Scholar] [CrossRef] [PubMed]
Disclaimer/Publisher’s Note: The statements, opinions and data contained in all publications are solely those of the individual author(s) and contributor(s) and not of MDPI and/or the editor(s). MDPI and/or the editor(s) disclaim responsibility for any injury to people or property resulting from any ideas, methods, instructions or products referred to in the content. |
© 2024 by the authors. Licensee MDPI, Basel, Switzerland. This article is an open access article distributed under the terms and conditions of the Creative Commons Attribution (CC BY) license (https://creativecommons.org/licenses/by/4.0/).